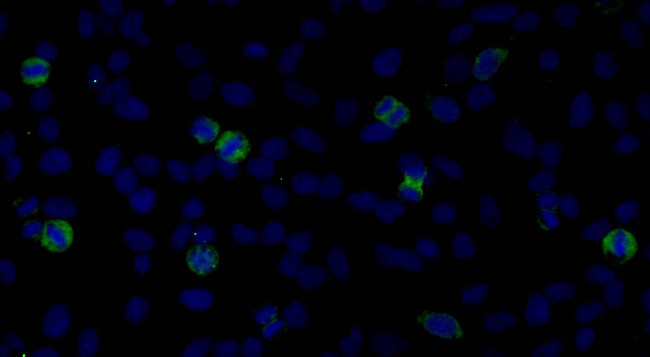
CENP-F/Mitosin Antibody in Immunocytochemistry (ICC/IF)

Search
Bethyl Laboratories
CENP-F/Mitosin Polyclonal Antibody
{{$productOrderCtrl.translations['antibody.pdp.commerceCard.promotion.promotions']}}
{{$productOrderCtrl.translations['antibody.pdp.commerceCard.promotion.viewpromo']}}
{{$productOrderCtrl.translations['antibody.pdp.commerceCard.promotion.promocode']}}: {{promo.promoCode}} {{promo.promoTitle}} {{promo.promoDescription}}. {{$productOrderCtrl.translations['antibody.pdp.commerceCard.promotion.learnmore']}}
图: 1 / 2
CENP-F/Mitosin Antibody (IHC-00065) in ICC/IF


产品信息
IHC-00065
种属反应
宿主/亚型
分类
类型
抗原
偶联物
形式
浓度
规格
纯化类型
保存液
内含物
保存条件
运输条件
产品详细信息
The recommended shelf life for this product is 1 year from date of receipt.
Based on 100% sequence identity, this antibody is predicted to react with Orangutan, Gorilla, Chimpanzee and Northern white-cheeked gibbon
靶标信息
This gene encodes a protein that associates with the centromere-kinetochore complex. The protein is a component of the nuclear matrix during the G2 phase of interphase. In late G2 the protein associates with the kinetochore and maintains this association through early anaphase. It localizes to the spindle midzone and the intracellular bridge in late anaphase and telophase, respectively, and is thought to be subsequently degraded. The localization of this protein suggests that it may play a role in chromosome segregation during mitosis. It is thought to form either a homodimer or heterodimer. Autoantibodies against this protein have been found in patients with cancer or graft versus host disease.
仅用于科研。不用于诊断过程。未经明确授权不得转售。
篇参考文献 (0)
生物信息学
蛋白别名: AH antigen; cell-cycle-dependent 350K nuclear protein; CENP-F; CENP-F kinetochore protein; Centromere protein F; centromere protein F, 350/400kDa; Kinetochore protein CENPF; Mitosin; RP11-262H5.1
基因别名: CENF; CENPF; CILD31; hcp-1; PRO1779; STROMS
UniProt ID: (Human) P49454
Entrez Gene ID: (Human) 1063